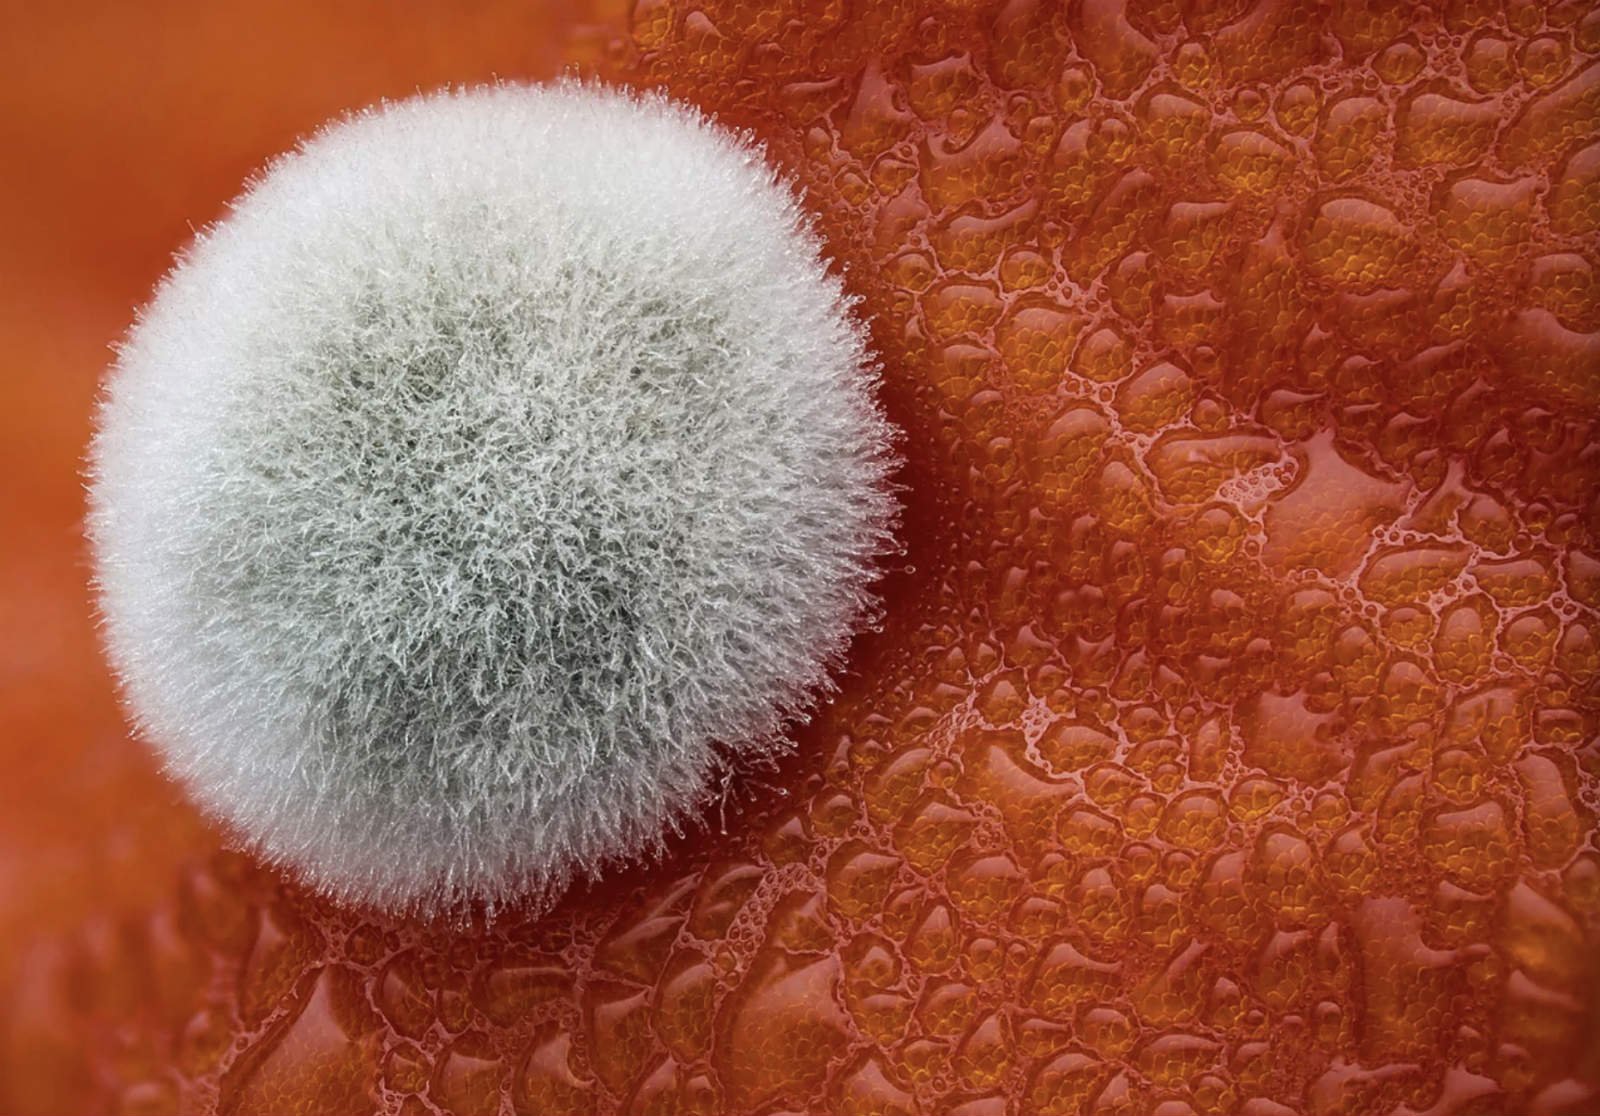

我们都知道科学很酷,同时它还美得惊人。每年尼康仪器都会举办尼康国际微距摄影世界杯,展现微距摄影的美,现在已经是第三十七届比赛了。任何对显微镜和摄影感兴趣的人都可以参加比赛。专家会根据原创性、信息内容、技术熟练程度和视觉冲击力判断图像。今年的获奖者在Instagram (@NikonInstruments)上宣布。
荷兰癌症研究所的Bram van den Broek拔得头筹,他在照片中展现了过量角蛋白。他在研究角蛋白丝动力学的时候偶然遇到了这个奇特且美丽的皮肤细胞。第二名是Havi Sarfaty捕捉的欧洲黄菀开花照片,这是菊科的一种。Sarfaty是一名兽医眼科医生,在显微镜下拍了大约八年的照片。最开始产生兴趣时因为它需要在显微镜下进行眼部手术,他也倾向于在花园里寻找拍摄对象。
优胜者的作品将以全彩日历的形式展出,作为国家博物馆游览过程的一部分,著名的科学和工业杂志也会使用这些照片作为封面。想要了解更多信息,可以访问nikonsmallworld.com。

(翻译:李君翔)
· · · · · · · · · · · · · · · · · · · · · · · · · · · · · · · · · · · · · · · · · · · · · · · · · · · · · · · · · · ·
想要获取更多有意思的内容,请移步界面网站首页(http://www.jiemian.com/),并在微博上和我们互动,调戏萌萌哒歪楼菌→【歪楼-Viral】(请猛戳这里)。






